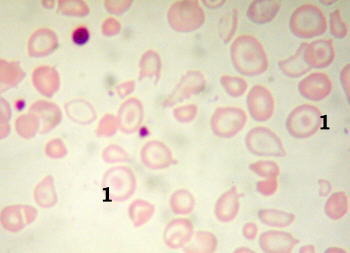

Praxis für Kinder- und Jugendmedizin - MVZ Fitz GmbH - Bernhard Hock - 67112 Mutterstadt
Folgende Schwerpunkte bieten wir in unserer Praxis an:
|
Neurodermitisberatung (Neurodermitistrainerausbildung AGNES) Dermatoskopie von verdächtigen Pigmentflecken
|
Diabetologie (HbA1c kapillär sofort) Mitglied im Pädiatrischen Diabetes-Schulungs-Netz Vorderpfalz INSU&LINI
Hämatologie/Onkologie (Gesamtes Blutbild und CRP kapillär sofort) Sonographie (Abdomen, Schädel,Hüfte,Schilddrüse, NNH, Herz, Weichteile) EKG,Pulsoxymetrie Ambulante 24 h Blutdruckmessung Jugendmedizin Jugenduntersuchung U10/U11//J1/J2 Allergologische Diagnostik und Therapie bei Atemwegserkrankungen Sportmedizinische Untersuchung (Ges. f. pädiatr. Sportmedizin) Stillberatung (Absolventin Basisseminare VELB) spezielle Schmerztherapie (Mitglied im Schmerz-Netz Rh.Pf) Impfungen und Vorsorgeuntersuchungen |
|
|